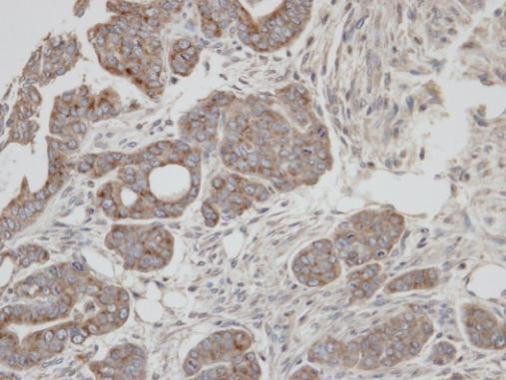
RAB2A Antibody in Immunohistochemistry (Paraffin) (IHC (P))
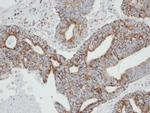
RAB2A Antibody in Immunohistochemistry (Paraffin) (IHC (P))

Search
Invitrogen
RAB2A Polyclonal Antibody
{{$productOrderCtrl.translations['antibody.pdp.commerceCard.promotion.promotions']}}
{{$productOrderCtrl.translations['antibody.pdp.commerceCard.promotion.viewpromo']}}
{{$productOrderCtrl.translations['antibody.pdp.commerceCard.promotion.promocode']}}: {{promo.promoCode}} {{promo.promoTitle}} {{promo.promoDescription}}. {{$productOrderCtrl.translations['antibody.pdp.commerceCard.promotion.learnmore']}}
产品信息
PA5-21754
宿主/亚型
分类
类型
抗原
偶联物
形式
浓度
规格
保存条件
运输条件
RRID
产品详细信息
Recommended positive controls: H1299, HeLaS3.
Predicted reactivity: Dog (100%), Rabbit (100%), Rhesus Monkey (100%), Chimpanzee (100%).
Store product as a concentrated solution. Centrifuge briefly prior to opening the vial.
靶标信息
Members of the Rab protein family are nontransforming monomeric GTP-binding proteins of the Ras superfamily that contain 4 highly conserved regions involved in GTP binding and hydrolysis. Rabs are prenylated, membrane-bound proteins involved in vesicular fusion and trafficking. The mammalian RAB proteins show striking similarities to the S. cerevisiae YPT1 and SEC4 proteins, Ras-related GTP-binding proteins involved in the regulation of secretion.
⚠WARNING: This product can expose you to chemicals including mercury, which is known to the State of California to cause birth defects or other reproductive harm. For more information go to www.P65Warnings.ca.gov.
仅用于科研。不用于诊断过程。未经明确授权不得转售。